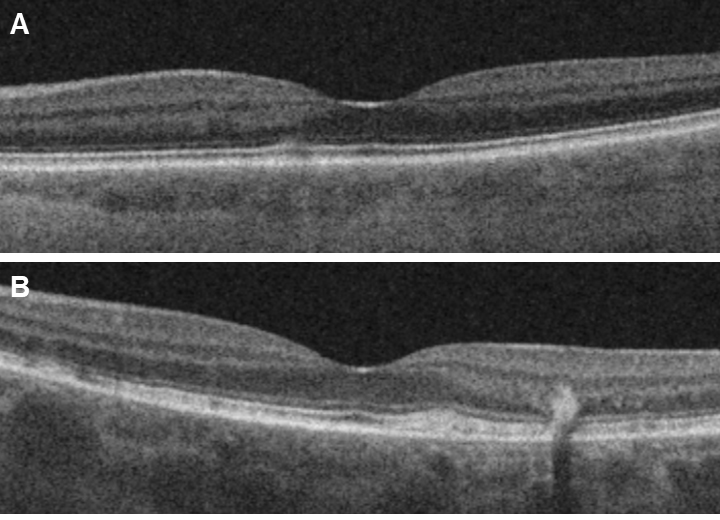

Figure 4. Optical coherence tomography. B-scans showing examples of A: mild changes with subtle outer retinal disruption (left eye of Subject 5) and B: alterations with more widespread outer retinal disruption (left eye of Subject 8) explained by the newly found additional
ABCA4 mutation.